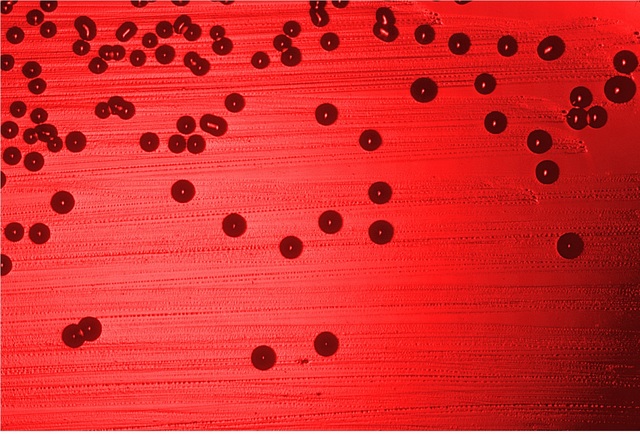
Sequenza di un genoma batterico

La Storia della Genetica: da Mendel alla Scoperta del Codice Genetico
-
Il biologo, matematico e monaco agostiniano ceco, Gregor Johan Mendel pubblica il suo lavoro sui piselli e le sue leggi.
Legge della dominanza
Legge della segregazione
Legge dell'assortimento indipendente
http://akitalupi.forumfree.it/?t=71248045 -
Miescher, biologo svizzero, isola per la prima volta gli acidi nucleici.
Gli trovó cercando di separare dal nucleo dei globuli bianchi componenti del citoplasm, egli trovo un acido che era composto per il 14% di azoto, 3% di fosforo e 2% di zolfo, fu chiamato nucleina e si pensava che serviva per immagazzinare il fosforo cellulare. Nel 1889 Richard Altmann proporá il ”termine acido nucleico” per chiamare la nucleina. -
Il biologo tedesco riuscì , grazie a una particolare tecnica di colorazione, a evidenziare nelle cellule in divisione la presenza di numerosi corpi a forma di bastoncino che furono detti cromosomi per la loro particolare affinità ai coloranti, scoprendo la mitosi
-
Francis Galton, cugino di Darwin, è stato un esploratore, antropologo e climatologo britannico e patrocinatore dell'eugenetica (teoria su come migliorare il genere umano attraverso “incroci selettivi”)
-
Il biologo e botanico tedesco Friedrich Leopold A. Weismann fu il primo ad intuire che la meiosi descritta in quel periodo fosse una divisione riduzionale per dotare i gameti della meta dei cromosomi.
-
Clarence Erwin McClung, biologista statounitense, chiarisce l’importanza dei cromosomi sessuali nella determinazione del sesso.
-
Boveri espose la tesi riguardante il significato differenziato dei cromosomi. Cioé che le cellule sottoposte a diminuzione davano origine alle cellule somatiche, quelli che invece non erano sottoposte a tale processo davano origine alle cellule germinali
-
Il biologo statunitense Walter Stanbourgh Sutton e il biologo tedesco Theodor Heinrich Boveri motivaronó la teoria cromosomica dell'ereditarietá candidandoli a contenitori dei "fattori medeliani"(geni)
-
Il medico inglese Archibald Garrod individua un rapporto tra i cromosomi e le attività metaboliche, capendo che l’alcaptonuria (anomalia genetica) dipede da una mutazione del fattore medeliano. 1ª prova di eredità mendeliana nell’uomo
-
Nettie Maria Stevens, genetista e microbiologa statunitense, e Edmund Beecher Wilso,genetista e zoologo statunitense attraverso ricerche indipendenti, furono i primi a descrivere la base cromosomica del sesso.
-
Il genetista Reignald Punnet e il biologo William Punnett,entrambi ingelsi, scoprono il fenomeno della associazione(linkage) tra i caratteri: geni associati sullo stesso cromosoma non segregano indipendemente ma insieme.
-
Il Matematico Godfrey H. Hardy trova il principio dell’equilibrio genetico di Hardy-Weinberg , scoperto mesi prima dal medico Wilhelm Weimberg, Date certe condizioni, le sequenze genetiche delle popolazione naturali rimangono costanti per molte generazioni.
-
Il maestro di genetica svedese Herman Nilsson-Ehle da la prova sperimentale che i caratteri con variazione continua sono controllati da multipli fattori mendeliani
-
il biochimico lituan Phoebus A. T. Levene scoprí il ribosio il quale é contenuto in ogni cellula e fa parte di strutture complesse quali l'acido ribonucleico, l'anno seguente formula l’ipotesi del tetracluotide che proponeva che il DNA fosse costituito dalle stesse quantitá di adenina, guanina, citosina e timina. Nel 1929 scopre il deossiribosio il quale porta a la creazione del DNA
-
Thomas Hunt Morgan scopre il linkage anche nella drosofila: quando i geni coinvolti nel controllo di certi caratteri erano vicini, fisicamente associati (linked) sullo stesso cromosoma, allora quei caratteri vengono trasmessi insieme. Si deduce che lungo i cromosomi i geni dovessero essere disposti in una sequenza lineare.
-
Propone su base teorica il fenomeno dello scambio di materiale genetico tra cromosomi omologhi permesso alla meiosi dal meccanismo di crossing over. Nascono le prime mappe cromosomiche.
-
Il genetista statunitense Alfred H. Sturtevant traccia la prima mappa di associazione, viene anche proposta l’associazione tra mutazione e selezione nei fenomeni evolutivi
-
Lo statista, matematico e biologo britannico Ronald Fisher pubblica i risultati delle sue ricerche sulle conseguenze evolutive dell’eredità mendeliana. 6 anni dopo elaborera una teoria sul origine della dominanza
-
Frederick Griffith dimostro che i Pneumococchi uccisi al calore possono trasformare ceppi non virulenti in virulenti
https://it.wikipedia.org/wiki/Esperimento_di_Griffith -
Oswald Theodore Avery, Colin Munro MacLeod e Maclyn McCarty dimostro che il DNA era il principio transformante della conversione di cellule batteriche di Diplococcus Pneumoniae da non virulente a virulunte, l'anno seguente dimostrarono che l’acido desossiribonucleico (DNA) era il portatore dei caratteri genetici.
https://it.wikipedia.org/wiki/Esperimento_di_Avery -
Il biochimico austriaco espose le sue regole dimostrando che i quattro nucleotidi sono presenti nel DNA, in cellule dello stesso organismo, in proporzioni stabili; ma in proporzioni diverse se consideriamo individui diversi
https://it.wikipedia.org/wiki/Regole_di_Chargaff -
Alfred Hershey e Martha Chase provarono il ruolo del DNA nell’ereditarietá.
https://it.wikipedia.org/wiki/Esperimento_di_Hershey-Chase -
James Watson e Francis Crick presentarono quello che oggi viene accertato come il primo modello accurato della struttura del DNA (doppia elica)
-
Joe Hin Tijo scopre casualmente nel laboratorio di Albert Levan che l'uomo ha 46 cromosi usando una nuova tecnica che impiegava la colchicina, perché deteneva la divisione cellulare in un punto dove i cromosomi erano chiaramente separati, e una soluzione salina ipotonica per separarli, cosi riuscii ad avere una chiara immagine dei cromosomi
https://es.wikipedia.org/wiki/Joe_Hin_Tjio#/media/File:Human_karyotype_(248_27)_Human_karyotype.jpg -
il biochimico e genetista Franklin Stahl insieme al genetista Matthew Meselson, entrambi statunitensi, condussero un esperimento nel quale dimostrarono che la replicazione del Dna era semiconservativa
https://it.wikipedia.org/wiki/Esperimento_di_Meselson-Stahl -
il genetista statunitense Howard Temin dimostra, usando virus a RNA, che il dogma centrale presenta delle eccezioni
-
La scoperta degli enzimi di restrizione è dovuta a Werner Arber, microbiologo svizzero, insieme a Daniel Nathans e Hamilton Smith. Questi complessi proteici sono in grado di rompere i legami fosfodiesterici del DNA a doppio filamento. Il ruolo biologico di questi enzimi è di protezione e salvaguardia della cellula: nei procarioti questi enzimi sono essenziali per il taglio e la degradazione di filamenti estranei al genoma
-
il biologo belga e il suo gruppo di lavoro sono stati i primi a determinare la sequenza di un gene, e nel 1976 la sequenza nucleotidica del fago RNA MS2
-
Il chimico britannico Frederick Sanger sequenziò con successo il genoma del batteriofago ΦX174, il primo genoma sequenziato completamente.
-
Il biochimico statunitense Kary Mullis sviluppa la tecnica della reazione a catena della polimerasi, comunemente nota con la sigla PCR, è una tecnica di biologia molecolare che consente la moltiplicazione di frammenti di acidi nucleici dei quali si conoscano le sequenze nucleotidiche iniziali e terminali.
https://www.youtube.com/watch?v=DkT6XHWne6E -
Il genetista britannico Alec Jeffreys inventa la tecnica della impronta genetica cioè il profilo derivato dalla applicazione di determinati marcatori molecolari ad un genoma, al fine di renderlo riconoscibile e rintracciabile.
-
Francis Collins e Lap-Chee Tsui sequenziarono il regolatore della conduttanza transmembrana della fibrosi cistica (CFTR), la quale se mutata puo provocare fibrosi cistica
-
Il coccobacillo Haemophilus influenzae che normalmente provoca otite media, sinusite, bronchite e polmonite viene sequenziato
-
Il Saccharomyces cerevisiae usato fin dall'antichità per la panificazione e la produzione di vino e birra viene sequenziato
-
Il verme Caenorhabditis elegans lungo circa 1 mm, che vive nel suolo, in regioni temperate, molto usato per lo studio della biologia dello sviluppo e dell'apoptosi viene sequenziato
-
Nel 2001 il proggeto Genoma umano viene annunciato, è stato un progetto di ricerca scientifica internazionale il cui obiettivo principale era quello di determinare la sequenza delle coppie di basi azotate che formano il DNA e di identificare e mappare i geni del genoma umano (previsti circa centomila, trovati circa 20-25000) dal punto di vista sia fisico sia funzionale. Nel 2003 viene completato il 98% del genoma umano con un livello di precisione del 99.99%
Plan projects on a visual timeline
Map milestones, phases, deadlines, and key events in one place so the sequence is easier to see and share. Timetoast is a timeline maker for work, school, research, and stories.